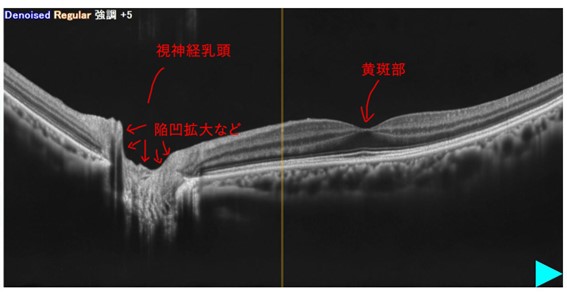

緑内障
緑内障は、眼球と脳をつなぐ視神経という器官が障害されて見えにくくなる疾患です。
例えるなら、景色をとらえるカメラである眼球が得た情報を、モニターである脳に送ろうとしても、カメラとモニターをつなぐケープルである視神経がダメになっていれば、満足な情報が伝達されず、質の悪い画像しか得られない状態に陥ってしまいます。
また、網膜をデジタル一眼レフカメラやミラーレス一眼のイメージセンサーに例えるなら、センサーの一部が悪くなりその部分だけ映像が得られない状態とも言えます。
眼圧について
眼圧の正常値は、10~20mmHgとされています。
(視神経の圧に耐えうる強さは個々に異なるため、その人の視神経が障害されない適正な眼圧は個人個人で差異があります。)
眼圧が20mmHgを超えていても、視神経が障害されず視野異常を来さない方もおります。
このような状態を「高眼圧症」と言います。
緑内障のタイプ
眼圧が高くなるタイプ
原発開放隅角緑内障
眼の排水口(隅角、線維柱帯)が目詰りして、眼圧が上がります。
原発閉塞隅角緑内障
眼の排水口が物理的に狭く(狭隅角)、眼圧が高くなります。
このタイプは突然に眼圧があがり(急性緑内障発作)、急に見えにくくなったり、目が痛くなったりします。
短期間で失明に至る怖いタイプでもあります。
内視鏡検査の前に緑内障の有無を聞かれると思いますが、このタイプが問題になります。
発作を起こす前に、前もって予防策としてレーザー手術を施しておくことは、安心につながります。
続発性緑内障
外傷、角膜疾患、眼内の炎症、ステロイド剤投与の副作用、網膜剥離、糖尿病網膜症などなんらかの原因により引き起こされる緑内障です。
眼圧が高くならないタイプ
正常眼底緑内障
開放隅角緑内障に含まれる緑内障です。
眼圧が高くなることはありませんが、正常範囲内の眼圧でもゆっくりと視神経がダメージを受けていき、眼圧の高くなる緑内障と同様の視野障害を起こします。
日本人にはこの正常眼底緑内障が多く、7割以上がこのタイプになります。
眼と脳をつなぐ視神経が圧に対して弱い場合や、視神経周りの血の巡りが悪い状態にある場合、特に近視が強いことによる視神経乳頭周囲の構造上の物理的問題が原因となるようです。
強度近視の人はそうでない人の2倍以上の確率で、正常眼圧緑内障になりやすいとのデータもあります。
緑内障の治療
基本的には点眼治療となります。
眼圧を下げる点眼薬を状態に応じて、単剤から複数の薬剤の併用まで行い、視野検査の結果を経時的にみながらコントロールしていきます。
レーザー治療や手術療法を行うこともあります。
緑内障の進行は止めることが出来ません。
加療により病状の進行を極力遅くし、「天寿を全うするまでなるべく視機能を保たせること」が基本的な考え方となります。
緑内障の検査
視力検査、眼圧検査はもちろんですが、眼底検査における視神経乳頭部の観察が重要です。
緑内障を強く疑った場合は、隅角検査、視野検査へと進めます。
緑内障学会のガイドラインにあるような、難しく専門的な表現ではなく、皆様にも解りやすい簡単な表現を用いポイントだけを述べていきます。
当院で実際に診察室で患者様にお見せして説明している内容となります。
- 眼底検査:眼底(網膜、視神経乳頭など)を観察する検査です。
- OCT検査:網膜や脈絡膜、視神経乳頭の形状、厚さ、むくみの有無などを鮮明に映し出してくれますので、診断に非常に有用な検査です。
- 視野検査:見える範囲を調べる検査です。緑内障や脳梗塞などの診断に使われます。
- 隅角検査:緑内障の種類を判別します。(必要な場合には行います。)
正常な眼底
正常眼底(左眼)を示します。
ぱっとみてキレイな印象だと感じられることと思います。
網脈絡膜萎縮
強い近視などにより、視神経乳頭部の周りに黄色や白色の変色した部分ができます。
機能が落ちるため、緑内障などに繋がることがあります。
正常な視神経乳頭部と比較してみましょう。
左:正常 視神経乳頭部写真 左眼 / 右:網脈絡膜萎縮を伴う視神経乳頭部写真 左眼

右の写真は、強度近視に伴う網脈絡膜萎縮がみられます。
写真の中央から右側の白っぽい部分です。
(この眼底の患者様は正常眼圧緑内障で点眼加療中です。)
このような変化のある眼底をみたら緑内障も考えながら診ていきます。
視神経乳頭陥凹拡大
検診や人間ドッグで指摘される事が多いものです。
これが結果表に書かれていたら、「緑内障の疑い」ということになります。
もちろん緑内障ではないことも非常に多いので、しっかりと的確に診てくれる眼科施設で相談しましょう。
生理的な視神経乳頭陥凹拡大といい、生まれつき凹みが大きい方もいます。
視力・眼圧・眼底・隅角・OCT検査など、総合的な判断が必要になります。
視神経乳頭部の直径に比して、凹みが大きく6割を超えてくるときに拡大と判断されます。
C/D比という言葉で表され、6割ならC/D=0.6となります。
正常 C/D=0.4

視神経乳頭陥凹拡大 左

この方は緑内障の点眼加療を行っています。
C/D=0.7~0.8となっており、視神経乳頭周辺に少しの網脈絡膜萎縮を伴っています。
同部の断層撮影 OCT画像です。
凹みを断面で表示してくれます。
神経繊維層欠損・神経繊維束欠損(NFLD)
※以後NFLDとします。
NFLDとは脳から来た神経繊維の束である視神経が、視神経乳頭部で四方八方に広がり網膜を形成しますが、傷んだ神経繊維がやせ細りその部分だけ薄くなり、眼底写真では網膜の下の脈絡膜がより透けて見えるため濃くみえる部分を言います。

視神経乳頭部から右上に弓なりの濃い部分がNFLDです。
右側はNFLDを実線で囲んでみました。

NFLDをOCT画像でみていきます。
網膜の厚みが同じ年齢層の平均に保たれている部分は、緑色に表示されます。
薄いところは赤く表示されます。
信号機と一緒です。
この方のNFLDに一致して、きれいに赤くなっているのがわかると思います。
(※説明のため解りやすい症例を選んでいます。)
実際の症例でみていきましょう。
自覚症状があり来院された症例
左眼の上の方が見えないことに気付き来院されました。
視力は矯正視力で、右(1.2) 左(0.6)、左眼の視力低下を認めます。
眼圧は正常、前房隅角は開放となっています。

左の下方にNFLDを認めます。

左眼下方の青く弓なりになっている部分(矢印)がNFLDです。

NFLDに一致し下側が赤く表示されています。
網膜の薄いエリアが解りやすくなりました。
眼の中心(黄斑部)にまで及ぶ赤い領域、これが視力低下の原因と予想されます。
視野検査を勧め、精査の段階へと進みます。
右眼 / 左眼

(視野は黒いところほど見えていない部分です。右眼の黒い丸は盲点です。)
本人の訴え通りに、中心にかかるように左眼上方が見えていません。
正常眼圧緑内障として、点眼加療を開始しました。
このように自覚されたり、インターネットなどにある緑内障セルフチェックから異常を感じ取り来院される方も多いです。
自覚症状がなく別の症状で来院した際に見つかった症例
飛蚊症の眼底検査希望で来院されました。
強度近視です。
以前は他院で何度か検査を行いましたが、飛蚊症はここ数年は検査をしていない。
飛蚊症は近視に伴うもので心配ありませんでした。
しかし、視神経乳頭陥凹拡大とNFLDを認めました。

右眼の下方に明瞭なNFLDを認めます!
OCT画像
右眼

眼底写真に一致し網膜の薄い場所が、明瞭に示されています。
厚みマップでは青く冷たい色で、正常眼データベースでは赤い表示となります。
左眼

眼底検査・眼底写真では解りにくかったNFLDがぼんやり浮かび上がります。
下方にうっすらと弓なりにNFLDがあります。
左眼にも異常が出始めていることがわかります。
右眼 / 左眼

左右ともに盲点から上方に広がる視野異常がみられます。
視野異常は明瞭なNFLDが存在する右眼に強くなっています。
視野異常は軽く自覚はなく、また正常眼圧緑内障で急に失明に至ることはないと考え、点眼無しで定期的な視野検査をしていき進行してきたら点眼を開始するか、やはり進行を気にするなら点眼を開始しながら経過をみていくか選択していただき、結果として点眼開始となりました。
最後に
緑内障について簡単に紹介してまいりました。
専門的にはさらに細かく奥の深いものとなりますが、皆様への紹介文ではわかりやすい項目にしぼり、かつ簡単な表現にさせていただいております。
40歳以上の方の20人に一人が緑内障とのデータもあります。
当院ではしっかりと診察し、緑内障かどうかを判断していきます。
定期検査だけ行う方、点眼加療を始めたほうが良い方など根拠となる診察結果をお見せして、説明し、ご自身の眼の状態をしっかりと理解していただけるように努めております。
眼の検診から治療まで、緑内障が気になる方はご相談ください。
- 診療内容
- 近視・遠視・乱視・老視
- 眼鏡・コンタクトレンズ処方
- 3歳までのスクリーニング検査
- 就学時健康診断・学校検診
- 斜視・弱視
- 眼精疲労
- ドライアイ
- 花粉症(アレルギー性結膜炎)
- 結膜炎
- ものもらい
- 飛蚊症・光視症(黒いものがとんだり光がみえる)
- 変視症(ものが歪んでみえる)
- 白内障
- 緑内障
- 糖尿病網膜症
- 加齢黄斑変性症
- その他網膜疾患(網膜剥離など)
- 心因性視力障害
- 不思議の国のアリス症候群





